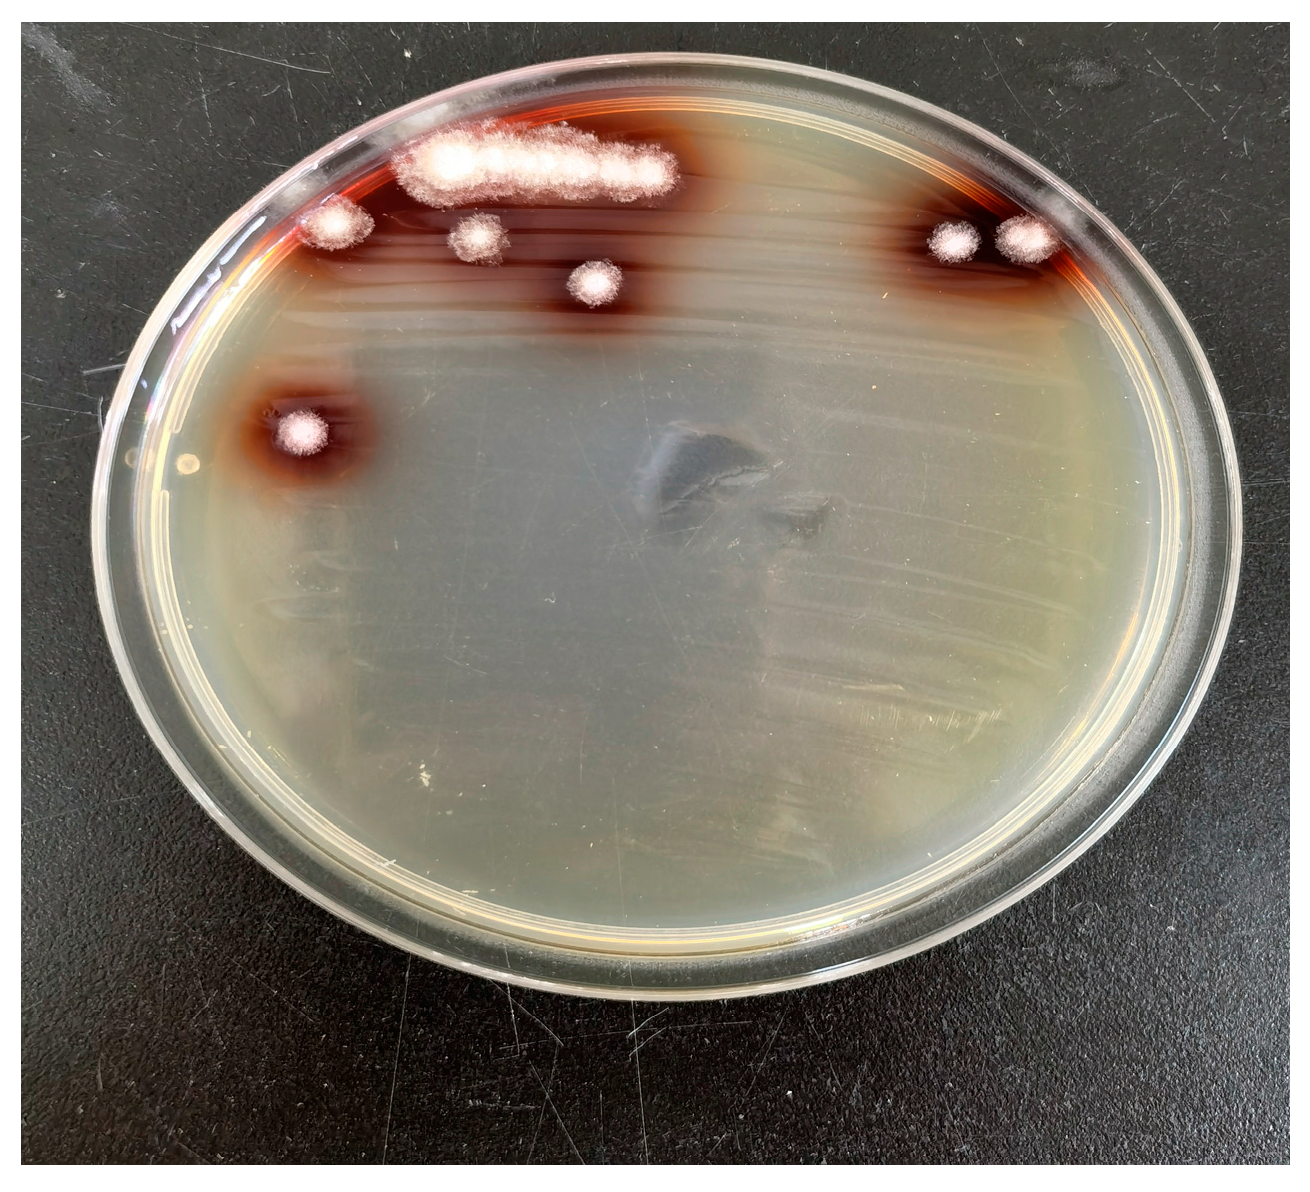
Agriculture 15 02376 g008 Agriculture 15 02376 g008

Microbial Divergence and Degradative Capacity During Straw Enrichment
Abstract
1. Introduction
2. Materials and Methods
2.1. Experimental Soil
2.2. Soil Physical and Chemical Properties Determination
2.3. Lignin Degradation Strains Isolation
2.4. Straw Degradation Rate Determination
2.5. Soil DNA Extraction and Microbial Community Structure Analysis
2.5.1. Genomic DNA Extraction and PCR Amplification
2.5.2. Library Preparation and Sequencing
2.5.3. Bioinformatic Analysis
2.6. Data Analysis
3. Results and Analysis
3.1. Diversity of Straw-Enriched Microbial Community
3.2. PCA of Straw-Enriched Microbial Community
3.3. Microbial Community Composition and Its Correlation with Environmental Factors
3.3.1. Composition Differences at the Phylum and Genus Levels of Straw-Enriched Bacteria
3.3.2. Differences in Fungal Composition at the Phylum and Genus Levels in Straw-Enriched Fungi
3.3.3. Correlation Analysis Between Straw-Enriched Bacteria and Fungi (Genus Level) and Environmental Factors
3.3.4. Prediction and Analysis of PICRUSt Function Under Soil Treatment in Different Regions
3.4. Isolation and Identification of Dominant Strains and Straw Degradation Effect
4. Discussion
5. Conclusions
- The predominant bacterial phyla enriched in the straw-amended soils across the four regions were Proteobacteria, Actinobacteriota, Firmicutes, and Chloroflexi. The dominant fungal phyla enriched under straw degradation were Ascomycota and Basidiomycota. These phyla encompass a substantial number of fungi and bacteria that play leading roles in straw decomposition.
- In the straw-enriched soils from the four regions, the relative abundance of the dominant bacterial genus, Bacillus, showed a positive correlation with the straw degradation rate but a negative correlation with pH. In contrast, the dominant fungal genera, Zopfiella and Chaetomium, exhibited positive correlations with both the straw degradation rate and pH. The enrichment of these two genera facilitates the rapid decomposition of straw.
- A Chaetomium strain, designated PC1, was isolated and screened from the PC-treated samples. Determination of its degradation capability revealed that strain PC1 achieved a rice straw degradation rate of 49.13%, which is higher than the 46.27% degradation rate observed in the pot-burial experiment under PC treatment. This result provides a theoretical foundation for screening indigenous high-efficiency microbial strains and developing compound microbial inoculants with direct practical application value.
Author Contributions
Funding
Data Availability Statement
Acknowledgments
Conflicts of Interest
References
- Maarastawi, S.A.; Frindte, K.; Bodelier, P.L.E.; Knief, C. Rice straw serves as additional carbon source for rhizosphere microorganisms and reduces root exudate consumption. Soil Biol. Biochem. 2019, 135, 235–238. [Google Scholar] [CrossRef]
- Ding, S.; Li, C.B.; Ding, X.Y.; Li, G.; Ban, G.; Xia, Z.; Zhao, X.; Lin, Q.; Wang, X. An exploration of manure derived N in soils using 15 N after the application of biochar, straw and a mix of both. Sci. Total Environ. 2022, 804, 150239. [Google Scholar] [CrossRef] [PubMed]
- Sun, Q.; Qiu, H.; Hu, Y.; Wei, X.; Chen, X. Cellulose and lignin regulate partitioning of soil phosphorus fractions and alkaline phosphomonoesterase encoding bacterial community in phosphorus-deficient soils. Biol. Fertil. Soils 2019, 55, 31–42. [Google Scholar] [CrossRef]
- Ghimire, R.; Norton, J.B.; Pendall, E.; Bista, P. Soil organic matter dynamics and microbial community composition under turfgrass expressed as ecosystem services. Geoderma 2018, 332, 116–124. [Google Scholar]
- Li, D.; Li, Z.; Zhao, B.; Zhang, J. Relationship between the chemical structure of straw and composition of main microbial groups during the decomposition of wheat and maize straws as affected by soil texture. Biol. Fertil. Soils 2020, 56, 11–24. [Google Scholar] [CrossRef]
- Zhang, P.; Chen, X.; Jia, Z.; Yang, B.; Wei, T. Effects of straw incorporation on the soil nutrient contents, enzyme activities, and crop yield in a semiarid region of China. Soil Tillage Res. 2016, 160, 65–72. [Google Scholar] [CrossRef]
- Azizirad, M.; Guggenberger, G.; Ma, Y.; Sierra, C.A. Sensitivity of soil respiration rate with respect to temperature, moisture and oxygen under freezing and thawing. Soil Biol. Biochem. 2022, 165, 108488. [Google Scholar] [CrossRef]
- Mo, F.; Zhu, Y.; Wang, Z.Y.; Deng, H.; Li, P.F. Polyethylene film mulching enhances the microbial carbon-use efficiency, physical and chemical protection of straw-derived carbon in an Entisol of the Loess Plateau. Sci. Total Environ. 2021, 792, 148357. [Google Scholar] [CrossRef]
- Li, P.; Li, Y.; Zheng, X.; Ding, L.; Ming, F. Rice straw decomposition affects diversity and dynamics of soil fungal community, but not bacteria. J. Soils Sediments 2018, 18, 248–258. [Google Scholar] [CrossRef]
- Xu, J.; Han, H.; Ning, T.; Li, Z.; Lal, R. Long-term effects of tillage and straw management on soil organic carbon, crop yield, and yield stability in a wheat-maize system. Field Crops Res. 2019, 233, 33–40. [Google Scholar] [CrossRef]
- Yang, H.; Li, Y.; Zhai, S.; Fang, C.; Liu, J.; Zhang, Q. Long term ditch-buried straw return affects soil fungal community structure and carbon-degrading enzymatic activities in a rice-wheat rotation system. Appl. Soil Ecol. 2020, 155, 103660. [Google Scholar] [CrossRef]
- Qiu, P.; Shao, J.; Ke, J.; Shao, H.; Shi, Z.; Wei, Z. Changes in soil microbial community, enzyme activities and organic matter fractions under long-term straw return in north-central China. Agric. Ecosyst. Environ. 2016, 216, 82–88. [Google Scholar]
- Su, X.; Wang, J.; Zhang, F.; Liu, J.; Gong, G.; Ouyang, X.; Wei, D.; Zhao, H. Microbial community succession associated with corn straw degradation in a bacterium consortium. Acta Microbiol. Sin. 2020, 12, 2675–2689. [Google Scholar]
- Li, P.; Li, Y.C.; Shi, J.L.; Zheng, X.Q.; Wu, G.G.; Jiang, W.; Zhao, K.; Ming, F.; Pan, A.H.; Lv, W.G.; et al. Effects of rice straw returning time on soil fungal community structure. Ecology 2017, 37, 4309–4317. [Google Scholar]
- Tan, Z.; Li, Q.; Chen, D.; Zhou, Q.; Xiao, Q.; Li, J. On the effect of rice-straw returned to the field on microbes and enzyme activity in paddy soil. J. Agric. Environ. Sci. 2006, 25, 670–673. [Google Scholar]
- Silva, J.P.; Ticona, A.R.P.; Hamann, P.R.V. Deconstruction of lignin: From enzymes to microorganisms. Molecules 2021, 26, 2299. [Google Scholar] [CrossRef]
- Khan, M.F. Fungi for Sustainable Pharmaceutical Remediation: Enzymatic Innovations, Challenges, and Applications-A Review. Processes 2025, 13, 1034. [Google Scholar] [CrossRef]
- Li, Y.; Chang, S.X.; Ali, T.; Chen, D.; Huang, Y.; Ao, J.; Jiang, Y.; Huang, Z. Linking soil fungal community structure and function to soil organic carbon chemical composition in intensive agricultural ecosystems. Appl. Soil Ecol. 2017, 117, 99–109. [Google Scholar]
- Torres-Farradá, G.; Thijs, S.; Rineau, F.; Guerra, G.; Vangronsveld, J. White rot fungi as tools for the bioremediation of xenobiotics: A review. Fungi 2024, 10, 167. [Google Scholar] [CrossRef]
- Ravi, S.Y.; He, W.; Liang, D.; Li, C.; Yu, Y. High-Efffciency Hydrogen Recovery from Corn Straw Hydrolysate Using Functional Bacteria and Negative Pressure with Microbial Electrolysis Cells. Water 2024, 16, 2423. [Google Scholar]
- Khan, M.F. Recent Advances in Microbial Enzyme Applications for Sustainable Textile Processing and Waste Management. Sci 2025, 7, 46. [Google Scholar] [CrossRef]
- BAO, S.D. Soil and Agricultural Chemistry Analysis, 3rd ed.; Agriculture Press: Beijing, China, 2000. [Google Scholar]
- Li, X.; Xu, L.; Wang, X.; Wang, J.; Su, Z. Effects of straw-decomposing microbial consortia and nutrient enhancement on the decomposition characteristics of rice straws in different returning ways. Chin. J. Ecol. 2019, 38, 2982–2988. [Google Scholar]
- Ge, Y.X. Effects of Rice Straw Returning on Soil Nutrition Balance and Nitrogen Utilization in Wheat and Its Ecological Mechanism; Nanjing Agricultural University: Nanjing, China, 2014. [Google Scholar]
- Chen, S.; Zhou, Y.; Chen, Y. fastp: An ultra-fast all-in-one FASTQ preprocessor. Bioinformatics 2018, 34, 884–890. [Google Scholar] [CrossRef] [PubMed]
- Magoč, T.; Salzberg, S.L. FLASH: Fast length adjustment of short reads to improve genome assemblies. Bioinformatics 2011, 27, 2957–2963. [Google Scholar] [CrossRef]
- Yuqing, Z.; Qian, W.; Fan, S.; Xiaoping, Y.; Yipeng, L.; Xuping, S. Effects of tebuconazole on insecticidal activity and symbionts in brown planthopper, Nilaparvata lugens (Hemiptera: Delphacidae). Pestic. Biochem. Physiol. 2025, 208, 106283. [Google Scholar] [CrossRef]
- Gregoriou, M.E. Genomic and transcriptomic analysis of the olive fly reproductive system, aiming at novel control methods. Bioresour. Technol. 2021, 319, 124107. [Google Scholar]
- Grzegorz, J.; Anna, P.; Justyna, S.; Urszula, S.; Anna, J. Lignin degradation: Microorganisms, enzymes involved, genomes analysis and evolution. Fems Microbiol. Rev. 2017, 41, 941–962. [Google Scholar]
- Zou, Q.; An, W.; Wu, C.; Li, W.; Fu, A.; Xiao, R.; Chen, H.; Xue, S. Red mud-modified biochar reduces soil arsenic availability and changes bacterial composition. Environ. Chem. Lett. 2018, 16, 615–622. [Google Scholar] [CrossRef]
- Wu, J.; Zhi, X.; Li, Y.; Guan, T.; Tang, S.; Xu, L.; Li, W. Comparison of Actinobacterial Diversity in Jiangcheng and Heijing Saline Mines in Yunnan by Using Culture-independent Approach. Acta Microbiol. Sin. 2008, 35, 1550–1555. [Google Scholar]
- Wu, C.; Shi, L.; Xue, S.; Li, W.; Jiang, X.; Rajendran, M.; Qian, Z. Effect of sulfur-iron modified biochar on the available cadmium and bacterial community structure in contaminated soils. Sci. Total Environ. 2019, 647, 1158–1168. [Google Scholar] [CrossRef]
- Kramer, C.; Gleixner, G. Soil organic matter in soil depth profiles: Distinct carbon preferences of microbial groups during carbon transformation. Soil Biol. Biochem. 2008, 40, 425–433. [Google Scholar] [CrossRef]
- Baker, B.J.; Lazar, C.S.; Teske, A.P.; Dick, G.J. Genomic resolution of linkages in carbon, nitrogen, and sulfur cycling among widespread estuary sediment bacteria. Microbiome 2015, 3, 14. [Google Scholar] [CrossRef] [PubMed]
- Zhang, H.L.; Bai, N.L.; Zheng, X.Q.; Li, S.; Zhang, J.; Zhang, H.; Zhou, S.; Sun, H.; Lv, W. Effects of straw returning and fertilization on soil bacterial and fungal community structures and diversities in rice-wheat rotation soil. Chin. J. Ecol. Agric. 2021, 29, 531–539. [Google Scholar]
- Zhao, S.; Qiu, S.; Xu, X.; Ciampitti, I.A.; Zhang, S.; He, P. Change in straw decomposition rate and soil microbial community composition after straw addition in different long-term fertilization soils. Appl. Soil Ecol. 2019, 138, 123–133. [Google Scholar] [CrossRef]
- Carniel, F.C.; Fortuna, L.; Zanelli, D.; Tretiach, M. Graphene environmental biodegradation: Wood degrading and saprotrophic fungi oxidize few-layer graphene. J. Hazard. Mater. 2021, 414, 125–135. [Google Scholar] [CrossRef]
- Zhou, D.X.; Wang, G.D.; Wu, X.H.; Ning, Y.; Li, J.; Li, L.; Cao, X. Compost isolation and enzymatic characteristics of cellulose-decomposing bacteria. J. Northeast Agric. Univ. 2018, 49, 60–68. [Google Scholar]
- Jiang, G.F.; Bao, Y.Z.; Yang, T.J.; Zheng, H.; Mei, X.; Wei, Z.; Xu, Y.; Shen, Q.R. Screening of thermophilic cellulolytic bacteria and investigation of cellulase thermostability. J. Agric. Environ. Sci. 2020, 39, 2465–2472. [Google Scholar]
- Wang, X.; Bai, J.; Wang, W.; Zhang, G.; Liu, X. Effects of Bacillus amyloliquefaciens biofertilizer on wheat straw degradation and soil microbial community. Appl. Soil Ecol. 2021, 158, 103781. [Google Scholar]
- Li, L.C.; Zhang, C.; Dong, Q.; Guo, C.; Zhou, B.; Gao, Z. Isolation and Identification of Cellulose Degrading Microorganisms in Composting Process. Biotechnol. Bull. 2019, 35, 165–171. [Google Scholar]
- Zhao, S.; Liu, J.; Chen, X. Synergistic effect of Streptomyces rochei and Trichoderma viride on the decomposition of maize straw. Bioresour. Technol. 2022, 343, 126100. [Google Scholar]
- Hassa, J.; Maus, I.; Off, S.; Pühler, A.; Scherer, P.; Klocke, M.; Schlüter, A. Metagenome, metatranscriptome and metaproteome approaches unraveled compositions and functional relationships of microbial communities residing in biogas plants. Appl. Microbiol. Biotechnol. 2018, 102, 6955–6969. [Google Scholar] [CrossRef]
- Wang, X.; Bai, J.; Xie, T.; Wang, W.; Zhang, G.; Yin, S.; Wang, D. Effects of straw returning and nitrogen fertilizer application on root-associated fungal community structure and functional gene abundance in soybean. Sci. Total Environ. 2021, 766, 144384. [Google Scholar]
- Tedersoo, L.; Bahram, M.; Põlme, S. Global diversity and geography of soil fungi. Science 2014, 346, 1256688. [Google Scholar] [CrossRef] [PubMed]
- Farhan, N.; Guo, Y.; Sumbal, S.; Hong, C.; Abdul, R.K.; Ting, C.; Xue, W.; Yun, H. Linking soil microbial community with the changes in soil physicochemical properties in response to long-term agricultural land use change of different chronosequences and depth layers. Ecol. Indic. 2022, 145, 109727. [Google Scholar] [CrossRef]
- Fierer, N.; Jackson, R.B. The diversity and biogeography of soil bacterial communities. Proc. Natl. Acad. Sci. USA 2006, 103, 626–631. [Google Scholar] [CrossRef]
- Sun, R.; Zhang, X.; Guo, X.; Wang, D.; Chu, H. Bacterial diversity in soils subjected to long-term chemical fertilization can be more stably maintained with the addition of livestock manure than wheat straw. Soil Biol. Biochem. 2015, 88, 9–18. [Google Scholar] [CrossRef]
- Bjorn, H.; Augustine, A.; Hannah, M.; Kaja, S.; Julia, F.; Lara, V.; Raymond, N.; Essa, A.; Trond, N.; Lisbet, S. Effects of exposure timing on cyp1a expression, PAH elimination, and lipid utilization in lumpfish embryos exposed to produced water. Environ. Sci. Technol. 2023, 57, 7666–7674. [Google Scholar]
- Zhuang, P.W.; Zhang, K.; Zheng, P.; Ling, M.; Zhang, Y.; Luo, Z. Lignin-degradation characteristics of deep-sea fungus Chaetomium sp.CS1. Mycosystema 2023, 42, 2442–2453. [Google Scholar]
- Liu, S. Screening of Straw Degradation Strains Under Mediumlow Temperature and Their Degradation Effects on Crop Straw; Chinese Academy of Agricultural Sciences: Beijing, China, 2011. [Google Scholar]
- Datta, R. Enzymatic degradation of cellulose in soil: A review. Heliyon 2024, 10, e24022. [Google Scholar] [CrossRef]

| Natural Condition | BS | LY | JO | PC | |
|---|---|---|---|---|---|
| Annual sunshine hours (h) | 1812.5 | 1704 | 1612 | 1635 | |
| Mean annual temperature (°C) | 19.5 | 17.8 | 19.3 | 17.6 | |
| Annual precipitation (mm) | 1350.9 | 1550 | 1700 | 1755 | |
| Soil physicochemical property | pH | 4.78 | 5.1 | 5.3 | 5.1 |
| Organic matter (g/kg) | 24.4 | 44.6 | 20.5 | 28.7 | |
| Total nitrogen (g/kg) | 1.23 | 2.86 | 1.13 | 1.82 | |
| Total phosphorus (g/kg) | 0.60 | 1.1 | 1.46 | 0.83 | |
| Total potassium (g/kg) | 13.3 | 14.7 | 12.6 | 28 | |
| Alkaline hydrolysis nitrogen (mg/kg) | 171.6 | 115.3 | 95.3 | 139.0 | |
| Available phosphorus (mg/kg) | 13.5 | 43.4 | 143.4 | 50.2 | |
| Available potassium (mg/kg) | 83.4 | 251 | 351 | 242 | |
| Microorganism | Treatment | Ace Index | Chao1 Index | Shannon Index | Coverage/% |
|---|---|---|---|---|---|
| Bacteria | BS | 1743.92 ± 160.96 a | 1719.65 ± 152.67 a | 6.10 ± 0.05 a | 99.77 ± 0.05 a |
| JO | 1529.22 ± 106.25 a | 1507.13 ± 103.61 a | 5.76 ± 0.17 a | 99.71 ± 0.12 a | |
| LY | 1577.53 ± 267.23 a | 1558.99 ± 254.65 a | 5.60 ± 0.25 a | 99.81 ± 0.14 a | |
| PC | 1575.41 ± 243.76 a | 1550.92 ± 231.51 a | 5.66 ± 0.06 a | 99.64 ± 0.25 a | |
| Fungi | BS | 110.20 ± 11.58 a | 109.76 ± 11.76 a | 2.09 ± 0.16 a | 99.99 ± 0.01 a |
| JO | 92.32 ± 10.74 a | 92.33 ± 10.73 a | 2.13 ± 0.57 a | 1 ± 0.00 a | |
| LY | 100.36 ± 9.14 a | 99.93 ± 9.42 a | 2.17 ± 0.03 a | 1 ± 0.00 a | |
| PC | 128.84 ± 26.65 a | 128.58 ± 27.22 a | 2.12 ± 0.15 a | 99.98 ± 0.01 a |
Disclaimer/Publisher’s Note: The statements, opinions and data contained in all publications are solely those of the individual author(s) and contributor(s) and not of MDPI and/or the editor(s). MDPI and/or the editor(s) disclaim responsibility for any injury to people or property resulting from any ideas, methods, instructions or products referred to in the content. |
© 2025 by the authors. Licensee MDPI, Basel, Switzerland. This article is an open access article distributed under the terms and conditions of the Creative Commons Attribution (CC BY) license (https://creativecommons.org/licenses/by/4.0/).
Share and Cite
Zhang, H.; Lin, C.; Chen, L.; Fang, Y.; Jia, X. Microbial Divergence and Degradative Capacity During Straw Enrichment. Agriculture 2025, 15, 2376. https://doi.org/10.3390/agriculture15222376
Zhang H, Lin C, Chen L, Fang Y, Jia X. Microbial Divergence and Degradative Capacity During Straw Enrichment. Agriculture. 2025; 15(22):2376. https://doi.org/10.3390/agriculture15222376
Chicago/Turabian StyleZhang, Hui, Chenqiang Lin, Longjun Chen, Yu Fang, and Xianbo Jia. 2025. "Microbial Divergence and Degradative Capacity During Straw Enrichment" Agriculture 15, no. 22: 2376. https://doi.org/10.3390/agriculture15222376
APA StyleZhang, H., Lin, C., Chen, L., Fang, Y., & Jia, X. (2025). Microbial Divergence and Degradative Capacity During Straw Enrichment. Agriculture, 15(22), 2376. https://doi.org/10.3390/agriculture15222376






